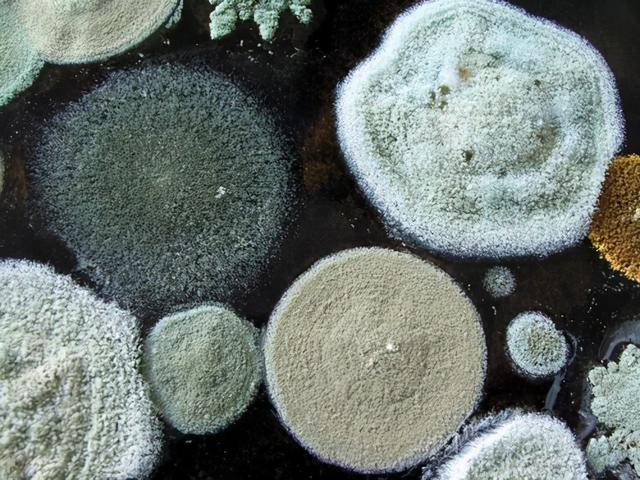
这2类“毒素”高温都烫不掉，为了家人健康，最好都扔掉不吃为妙

这2类“毒素”高温都烫不掉,为了家人健康,最好都扔掉不吃为妙( 二 )
人误食黄曲霉毒素后 , 轻则会出现腹胀、胃痛、呕吐、肠鸣 , 严重情况下会出现黄疸、上腹部疼痛、体重极速下降等等 。
 文章插图
文章插图
如何避免黄曲霉毒素中毒?
在避免黄曲霉毒素上 , 建议大家远离发霉的食物 , 即便是有一点发霉迹象 , 整个食物也不要再吃了;对于厨房用具 , 需要大家定期更换 , 如筷子可每3个月更换一次 。
文章插图
文章插图
米酵菌酸:米酵菌酸是什么?
米酵菌酸是大家近几年比较熟悉的一种毒素 , 根据它的特点 , 主要是由椰毒假单胞菌属酵米面亚种产生的一种会引发人食物中毒的毒素 , 不仅会引发动物中毒 , 对人来说也会中毒甚至死亡 。
据中国经济网报道 , 2020年10月5号 , 黑龙江有9人因家庭聚餐食用了“酸汤子”随后中毒或死亡 。 在相关调查中 , 发现变质的菌菇类食材、玉米面制品以及其他淀粉类的食物 。
在储藏不当的情况下 , 极易诱发人食物中毒 , 由于这种毒素普通烹饪消灭不掉 , 人吃后极易中毒 。 即便是夏天的高温日晒也很难祛除掉它的毒素 , 可以严重威胁人的身体健康 。
 文章插图
文章插图
米酵菌酸中毒后会有哪些反应?
研究学者发现 , 人在吃完富含米酵菌酸的食物之后 , 短则在2个小时之内 , 最迟也会在24个小时之内出现腹泻、恶心、呕吐、头晕、全身乏力、烦躁不安等不适 , 病死率可高达40%以上 。
 文章插图
文章插图
如何避免米酵菌酸中毒?
为了避免米酵菌酸中毒 , 建议喜欢吃发酵类食物的人群 , 一定要注意卫生、勤换水、吃之前仔细检查食物是否有异样(如味道有异味、颜色异常、发霉等) , 就不要想着再用普通的烹饪方式去掉毒素了 , 容易增加米酵菌酸中毒的概率 。
如果大家想要避免最好的办法还是少用自制的美食 , 想要吃的话可以去正规超市购买 , 食用时一是要注意开封后尽早吃完 , 二是最好选择真空包装的发酵制品 , 安全性更高 。
 文章插图
文章插图
写在最后:
提醒大家 , 食物固然美味能够满足味蕾的要求 , 但重点还是希望大家可以吃得健康安全 , 远离明知道会影响身体健康的食物 。
其中也包括世界卫生组织国际癌症机构公布的1类致癌物 , 如烟草、酒精、上面提到的黄曲霉毒素、槟榔、石棉等等 。
如果你作为一名家庭主妇更应该担起全家人营养的责任 , 不仅是在为自己的身体健康负责更是为了家人的健康着想 , 有了身体才会有革命的本钱 。 尤其是厨房中的各种食材新鲜程度、厨房用具的使用情况 , 都需要注意哦~
推荐阅读
- 甘油三酯和胆固醇水平高,应该怎么办?提醒:2类食物最好少吃
- 高血脂的朋友,这2类食物要少吃!医生详细总结
- 肺痨最爱盯上2类人,可出现这些早期症状,别忽略了
- 五年抗癌经历,齐先生用经验告诉你,抗癌不能少了它
- 温开水|为什么晨起要喝一杯温开水?
- 这种富含「致癌毒素」的油,千万别再让爸妈吃了
- 吃了盘长寿菜,6人肾损伤!3种蔬菜自带毒素,吃前要做好1件事
- 肝不好,多喝这5种“水”,及时排出肝脏的毒素,远离肝病困扰
- 便秘|便秘会让体内毒素增多!“宿便”都去哪里了?
- 每天一小杯,可杀死体内癌细胞!可以排出身体10年的毒素

















